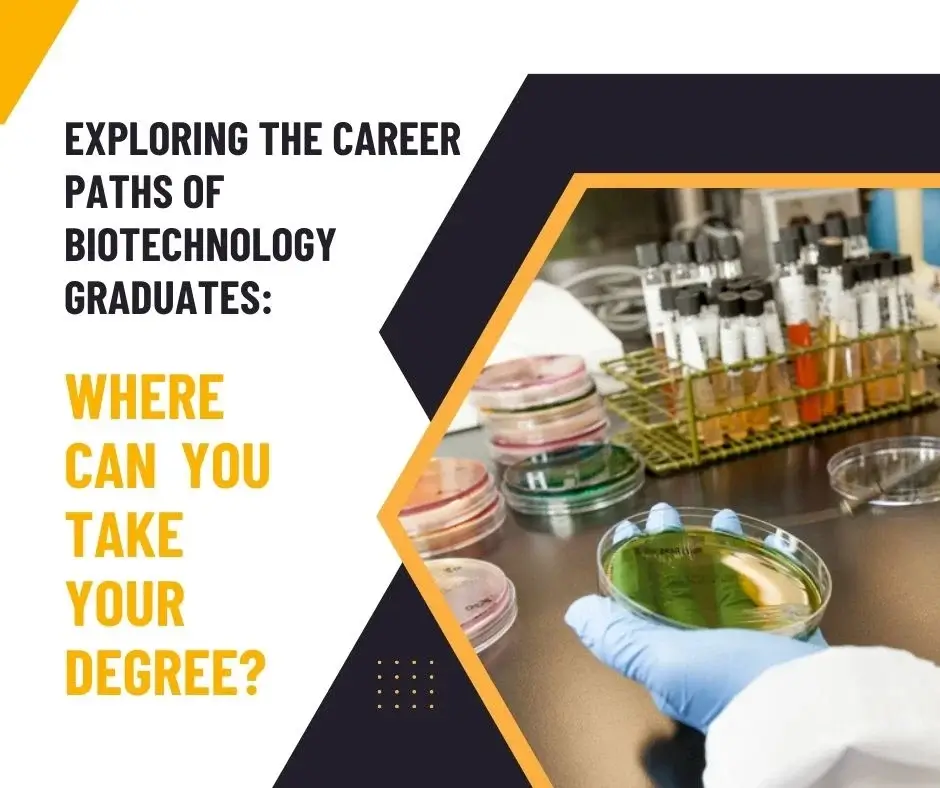
Exploring the Career Paths of Biotechnology Graduates: Where Can You Take Your Degree?

Leading the Way: Discover Chandigarh's Best MBA Colleges
19th May, 2023
Choosing the best MBA college is a critical decision that can shape your career in the field o...
Explore More

19th May, 2023
Choosing the best MBA college is a critical decision that can shape your career in the field o...
Explore More
18th May, 2023
BCA, or Bachelor of Computer Applications, is a three years undergraduate program. It imparts studen...
Explore More
17th May, 2023
Are you planning to do BBA? It is a preferred career option for students who want to build their car...
Explore More
16th May, 2023
Master Of Computer Application is a specialized post-graduate course in computer science. It is a tw...
Explore More
12th May, 2023
In today's dynamic business landscape, obtaining a Master of Business Administration (MBA) degree is...
Explore More
11th May, 2023
Are you stuck in your career and looking for ways to take it to the next level? If so, an MBA might...
Explore More
10th May, 2023
We all know that Class 12th is the most crucial year in any student’s life. It is considered a...
Explore More
08th May, 2023
Mechanical engineering is a field that has captured the imagination of many young minds over the yea...
Explore More
04th May, 2023
Do you have a passion for science and technology? Are you interested in using your skills to make gr...
Explore More
03rd May, 2023
Why Cybersecurity Professionals are in High Demand in Today's Job Market? Cybersecurity has becom...
Explore More
02nd May, 2023
Are you a pharmacy graduate looking to jumpstart your career and maximise your income? In this blog...
Explore More
01st May, 2023
Are you a law student looking for ways to enhance your legal skills and gain practical experience in...
Explore More
29th April, 2023
One of the most sought-after engineering programs among students is computer science engineering. Co...
Explore More
29th April, 2023
Artificial Intelligence (AI) is one of the world's most widely discussed technologies nowadays. AI i...
Explore More
28th April, 2023
Are you a business-minded individual looking to pursue a Bachelor of Business Administration (BBA) d...
Explore More
26th April, 2023
Are you interested in pursuing a cybersecurity career but unsure which degree to choose? Look no fur...
Explore More
26th April, 2023
Are you interested in pursuing a career in Nutrition and Dietetics? Look no further than Chandigarh...
Explore More
25th April, 2023
Are you ready to take your career to new heights? Do you want to gain the skills and knowledge neces...
Explore More
25th April, 2023
Are you always curious about what's happening around the world? Do you enjoy reading newspapers, wat...
Explore More
24th April, 2023
Are you interested in technology and wish to pursue a career in engineering? If so, it’s time...
Explore More
22nd April, 2023
Are you passionate about healthcare and interested in pursuing a career in the pharmaceutical indust...
Explore More
17th April, 2023
Are you someone who is passionate about the law and wants to pursue a career in this field? Do you d...
Explore More
13th April, 2023
Studying law will equip you to deal with legal and personal challenging issues. You will be able to...
Explore More
12th April, 2023
Chandigarh Group of Colleges Jhanjeri is one of the most prominent educational institutions in India...
Explore More